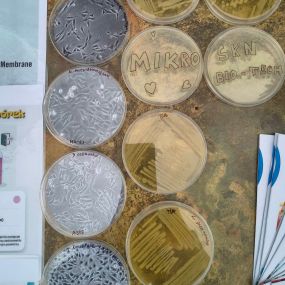

Aktualności
Studenckie Koła Naukowe Wydziału Biotechnologii na wydarzeniu „Kolaż Kół Naukowych”
16 kwietnia 2026 r. członkowie SKN BIO-TECH oraz SKN Browarników, wzięli udział w wydarzeniu „Kolaż Kół Naukowych”, zorganizowanym przez WSPiA.
Spotkanie stanowiło przestrzeń integracji środowiska akademickiego oraz wymiany doświadczeń między przedstawicielami kół naukowych działających w różnych obszarach, takich jak inżynieria i nowe technologie, biznes i marketing, prawo i administracja, a także medycyna i nauki o zdrowiu.
Dziękujemy wszystkim uczestnikom za zainteresowanie oraz inspirujące rozmowy.